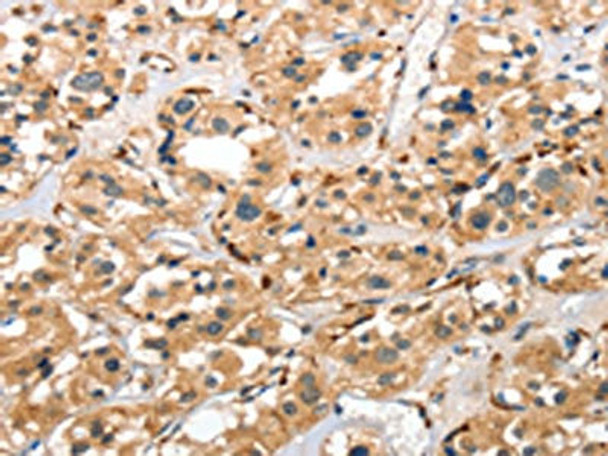
The image on the left is immunohistochemistry of paraffin-embedded Human thyroid cancer tissue using CSB-PA296813 (CTSE Antibody) at dilution 1/40, on the right is treated with fusion protein. (Original magnification: ×200) The image on the left is immunohistochemistry of paraffin-embedded Human thyroid cancer tissue using CSB-PA296813 (CTSE Antibody) at dilution 1/40, on the right is treated with fusion protein. (Original magnification: ×200)

Cusabio Polyclonal Antibodies
CTSE Antibody | CSB-PA296813
- SKU:
- CSB-PA296813
- Availability:
- 3 to 7 Working Days
Description
CTSE Antibody | CSB-PA296813 | Cusabio
CTSE Antibody is Available at Gentaur Genprice with the fastest delivery.
Online Order Payment is possible or send quotation to info@gentaur.com.
Product Type: Polyclonal Antibody
Target Names: CTSE
Aliases: Cathepsin E
Background: The protein encoded by this gene is a gastric aspartyl protease that functions as a disulfide-linked homodimer. This protease, which is a member of the peptidase C1 family, has a specificity similar to that of pepsin A and cathepsin D. It is an intracellular proteinase that does not appear to be involved in the digestion of dietary protein and is found in highest concentration in the surface of epithelial mucus-producing cells of the stomach. It is the first aspartic proteinase expressed in the fetal stomach and is found in more than half of gastric cancers. It appears, therefore, to be an oncofetal antigen. Transcript variants utilizing alternative polyadenylation signals and two transcript variants encoding different isoforms exist for this gene.
Isotype: IgG
Conjugate: Non-conjugated
Clonality: Polyclonal
Uniport ID: P14091
Host Species: Rabbit
Species Reactivity: Human, Mouse, Rat
Immunogen: Fusion protein of human CTSE
Immunogen Species: Human
Applications: ELISA, WB, IHC
Tested Applications: ELISA, WB, IHC;ELISA:1:1000-1:5000, WB:1:500-1:2000, IHC:1:50-1:200
Purification Method: Antigen affinity purification
Dilution Ratio1: ELISA:1:1000-1:5000
Dilution Ratio2: WB:1:500-1:2000
Dilution Ratio3: IHC:1:50-1:200
Dilution Ratio4:
Dilution Ratio5:
Dilution Ratio6:
Buffer: -20°C, pH7.4 PBS, 0.05% NaN3, 40% Glycerol
Form: Liquid
Storage: Upon receipt, store at -20°C or -80°C. Avoid repeated freeze.
Initial Research Areas: Immunology
Research Areas: Immunology